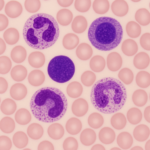
Leucocytes

La phosphatase alcaline (ALP) est une enzyme essentielle présente dans tout votre corps. Sa mesure, via un simple test sanguin, est cruciale pour évaluer la santé de votre foie et de vos os. Si votre médecin vous a prescrit un tel examen ou si vous souhaitez en savoir plus sur cette enzyme clé, cet article est fait pour vous.
Un test d’ALP mesure spécifiquement le niveau de cette enzyme provenant de votre foie et de vos os dans votre sang. Souvent inclus dans un bilan métabolique complet, des niveaux anormaux d’ALP peuvent être le signe de maladies hépatiques ou de certains troubles osseux.
Qu’est-ce que la Phosphatase Alcaline (ALP) ?
La phosphatase alcaline (ALP) est une enzyme, un type de protéine cellulaire agissant comme un catalyseur pour de nombreux processus corporels. Bien que sa fonction exacte soit encore étudiée, les chercheurs estiment qu’elle joue un rôle fondamental dans plusieurs mécanismes vitaux.
L’ALP est principalement présente dans votre foie, c’est pourquoi on la considère souvent comme une enzyme hépatique. Cependant, on la retrouve également dans :
- Votre canal biliaire
- Vos os
- Vos reins
- Vos intestins
- Le placenta chez les femmes enceintes
Des niveaux anormaux d’ALP dans votre sang sont un indicateur potentiel de dommages aux tissus ou d’une perturbation des processus corporels normaux.
Le Test Sanguin de la Phosphatase Alcaline (ALP) : Ce qu’il Faut Savoir
Qu’est-ce qu’un test sanguin d’ALP ? Un test sanguin d’ALP mesure la quantité de cette enzyme dans votre sang. Bien que l’ALP soit présente dans tout le corps, les deux sources principales de l’ALP sanguine sont le foie et les os. Des niveaux élevés peuvent suggérer une maladie hépatique ou des troubles osseux, mais il est crucial de noter qu’un test ALP seul ne suffit pas à poser un diagnostic définitif.
Il existe deux types principaux de tests ALP : le test ALP général (le plus courant) et le test d’isoenzyme d’ALP. Le test général est souvent intégré à un bilan métabolique complet (BMC) ou à un bilan hépatique.
Le test d’isoenzyme d’ALP, plus complexe et coûteux, permet de distinguer l’origine de l’ALP (foie, os, etc.), et est généralement effectué en suivi d’un résultat anormal au test ALP général.
Pourquoi votre médecin pourrait-il prescrire un test d’ALP ? Votre professionnel de la santé peut commander un test sanguin d’ALP pour diverses raisons :
- Dépistage : Souvent inclus dans les bilans de routine, il permet de détecter des problèmes de santé potentiels avant l’apparition des symptômes.
- Surveillance : Si vous souffrez déjà d’une affection hépatique ou osseuse, le test ALP aide à suivre l’évolution de votre état et l’efficacité du traitement.
- Diagnostic : En présence de symptômes suggérant des problèmes hépatiques ou osseux, l’ALP fait partie du processus diagnostique. Bien qu’elle ne diagnostique pas à elle seule une maladie, l’ampleur de l’élévation ou de la diminution de l’ALP peut orienter le diagnostic et la gravité de la condition.
Signes et symptômes de maladie hépatique :
- Ictère (jaunissement de la peau et des yeux)
- Douleur et/ou gonflement abdominal (en particulier côté droit)
- Ecchymoses faciles
- Nausées et/ou vomissements
- Urine foncée et/ou selles claires
- Perte de poids inexpliquée
- Fatigue
- Gonflement des bras ou des jambes (œdème)
Signes et symptômes de troubles osseux :
- Douleur osseuse et/ou articulaire
- Os élargis et/ou de forme anormale
- Augmentation des fractures osseuses
Différence entre un test ALP et un bilan hépatique/BMC Un bilan hépatique ou un bilan métabolique complet (BMC) sont des tests en panel qui mesurent plusieurs paramètres sanguins, offrant une vision plus globale de votre santé, en particulier de la fonction hépatique. Le test ALP est généralement une composante de ces bilans, complétant d’autres mesures pour une image plus complète.
Le Déroulement du Test Sanguin d’ALP
Qui réalise la prise de sang ? Un phlébotomiste ou tout professionnel de la santé formé à la prise de sang effectuera le prélèvement. L’échantillon est ensuite analysé en laboratoire (laboratoire CTRS) par un scientifique médical.
Faut-il jeûner avant un test ALP ? Si votre test ALP fait partie d’un bilan métabolique complet (BMC), un jeûne de 10 à 12 heures (uniquement de l’eau) est souvent requis. Suivez toujours les instructions spécifiques de votre médecin.
À quoi s’attendre pendant le test ? La procédure est rapide et simple : un professionnel insérera une petite aiguille, généralement dans le pli de votre coude, pour prélever un échantillon de sang. Vous pourriez ressentir une légère piqûre. La procédure dure généralement moins de cinq minutes.
Après le test Une fois l’échantillon prélevé, il est envoyé au laboratoire pour analyse. Votre médecin partagera les résultats avec vous dès qu’ils seront disponibles.
Risques du test ALP Les tests sanguins sont très sûrs. Vous pourriez ressentir une légère sensibilité ou avoir une ecchymose au site de la prise de sang, mais cela se résout généralement rapidement.
Délais pour les résultats Dans la plupart des cas, vous devriez recevoir vos résultats dans un à deux jours ouvrables, bien que cela puisse parfois prendre un peu plus de temps.
Comprendre vos Résultats de Test ALP
Interprétation générale des rapports Les rapports de tests sanguins, y compris ceux de l’ALP, incluent généralement :
- Le nom du test et la mesure effectuée.
- Votre résultat numérique.
- La plage de référence normale du laboratoire.
- Une indication si votre résultat est normal, anormal, élevé ou bas.
Quelle est la plage normale pour l’ALP ? La plage normale d’ALP varie d’un laboratoire à l’autre (par exemple, 44 à 147 UI/L ou 30 à 120 UI/L). Il est donc essentiel de vous référer à la plage de référence spécifique indiquée sur votre rapport.
Il est également important de noter que les niveaux d’ALP varient avec l’âge et le sexe. Ils sont souvent élevés pendant l’enfance et la puberté en raison de la croissance osseuse. Ils peuvent aussi être plus élevés chez les femmes enceintes ou lors de la guérison de fractures.
Que signifie un taux d’ALP élevé ? Un niveau élevé d’ALP peut indiquer des dommages au foie ou un trouble osseux. L’ALP provenant du foie est différente de celle provenant des os. Si votre taux d’ALP est élevé, votre médecin pourra demander des tests supplémentaires, comme un test d’isoenzyme d’ALP, pour identifier l’origine de l’excès.
Causes possibles d’ALP hépatique élevée :
- Cholestase de la grossesse
- Cirrhose du foie
- Hépatite
- Atrésie biliaire (chez les nourrissons)
- Sténose biliaire
- Obstruction biliaire due à un cancer
- Mononucléose
Causes possibles d’ALP osseuse élevée :
- Métastases osseuses (propagation de cellules cancéreuses aux os)
- Maladie de Paget de l’os
- Sarcome ostéogénique (cancer des os)
- Fractures en cours de guérison
- Hyperparathyroïdie ou Hyperthyroïdie
- Ostéomalacie (souvent due à une carence en vitamine D)
- Maladie cœliaque non traitée
Il est à noter qu’une légère élévation de l’ALP n’indique pas toujours une condition grave et peut être surveillée dans le temps.
Que signifie un taux d’ALP bas ? Un niveau anormalement bas d’ALP est moins courant mais peut indiquer :
- Malnutrition
- Carence en zinc ou en magnésium
- Hypothyroïdie
- Conditions génétiques rares (hypophosphatasie, maladie de Wilson)
Faut-il s’inquiéter d’un résultat d’ALP anormal ? Un résultat d’ALP élevé ou bas ne signifie pas automatiquement une maladie nécessitant un traitement. D’autres facteurs comme certains médicaments (pilules contraceptives), le régime alimentaire, la grossesse, l’âge (adolescents et enfants), le SIDA, ou des erreurs de laboratoire peuvent influencer les niveaux.
Votre professionnel de la santé évaluera vos résultats en tenant compte de vos antécédents médicaux, de vos médicaments actuels, des résultats d’autres tests et de vos symptômes avant de décider si des examens complémentaires sont nécessaires.
Quand Contacter Votre Médecin ?
Si vous ressentez des symptômes de lésions hépatiques (comme l’ictère) ou de troubles osseux (douleur osseuse ou articulaire), contactez votre professionnel de la santé. Si vous êtes déjà diagnostiqué avec une condition hépatique ou osseuse et que de nouveaux symptômes apparaissent, parlez-en à votre médecin traitant.
N’hésitez jamais à poser des questions à votre fournisseur de soins concernant vos résultats d’ALP. Il est là pour vous aider à comprendre votre santé.
Une Note Importante
Voir un résultat de test anormal peut être une source de stress. Sachez qu’avoir un niveau élevé ou bas de phosphatase alcaline ne signifie pas nécessairement que vous avez une condition médicale et que vous avez besoin d’un traitement. Environ une personne en bonne santé sur 20 a des résultats de test en dehors de la plage normale. Votre professionnel de la santé vous fera savoir si vous devez subir d’autres tests pour déterminer la cause du niveau anormal. N’hésitez pas à poser des questions à votre médecin. Il est là pour vous aider.
Foire Aux Questions (FAQ) sur la Phosphatase Alcaline (ALP)
1. Que signifie un taux élevé de phosphatase alcaline ? Un taux élevé de phosphatase alcaline (ALP) dans le sang peut indiquer un problème au niveau du foie ou des os, qui sont les principales sources de cette enzyme. Cela peut suggérer des dommages hépatiques, une cholestase, ou divers troubles osseux comme la maladie de Paget, des fractures en cours de guérison, ou même des métastases osseuses. D’autres facteurs comme la grossesse peuvent aussi élever l’ALP.
2. Quel est le taux inquiétant de phosphatase alcaline ? Il n’y a pas de “taux inquiétant” universel, car la plage normale d’ALP varie selon les laboratoires, l’âge, le sexe, et d’autres facteurs comme la grossesse. Généralement, un taux significativement supérieur à la plage de référence de votre laboratoire (par exemple, au-delà de 147 UI/L ou 120 UI/L selon la norme) est considéré comme élevé. Cependant, même une légère élévation nécessite une évaluation médicale pour en déterminer la cause et la pertinence clinique.
3. Qu’est-ce qui fait augmenter la phosphatase alcaline ? Plusieurs conditions et facteurs peuvent faire augmenter la phosphatase alcaline :
- Problèmes hépatiques : Cholestase (blocage des canaux biliaires), hépatite, cirrhose.
- Problèmes osseux : Maladie de Paget, fractures en guérison, ostéomalacie, hyperparathyroïdie, cancers des os ou métastases osseuses.
- Autres causes : Grossesse, croissance rapide chez les enfants et adolescents, certains médicaments, carences (vitamine D non spécifiée directement dans le texte d’origine pour l’élévation, mais la carence en Vit D cause l’ostéomalacie), hyperthyroïdie, ou dans de rares cas la mononucléose ou la maladie cœliaque non traitée.
4. Quels cancers augmentent la phosphatase alcaline ? Plusieurs types de cancers peuvent entraîner une augmentation de la phosphatase alcaline, principalement en raison de leur impact sur le foie ou les os :
- Cancers avec métastases osseuses : Lorsque des cellules cancéreuses se propagent aux os (par exemple, cancers du sein, prostate, poumon, rein).
- Cancers du foie ou des voies biliaires : Comme le cholangiocarcinome ou d’autres cancers qui peuvent bloquer les canaux biliaires ou endommager le foie.
- Cancers primaires des os : Tels que le sarcome ostéogénique.